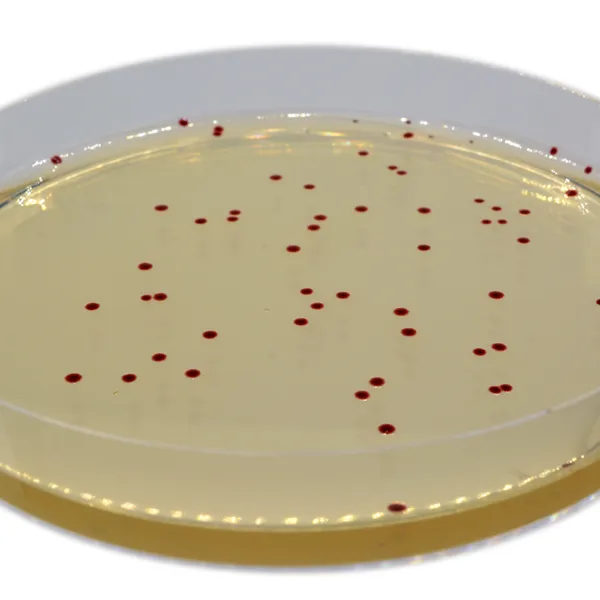
CHROMagar™ Campylobacter

Colonies Appearance

Campylobacter jejuni, coli, lari
red
Performance
Performance
“Campylobacter bacteria are a major cause of foodborne diarrhoeal illness in humans and are the most common bacteria that cause gastroenteritis worldwide. In developed and developing countries, they cause more cases of diarrhoea than foodborne Salmonella. The high incidence of Campylobacter diarrhoea, as well as its duration and possible sequelae, makes it highly important from a socio-economic perspective. In developing countries, Campylobacter infections in children under the age of two years are especially frequent, sometimes resulting in death.”
World Health Organisation (WHO) – fact sheet N°255
Campylobacter spp. are fastidious bacteria that may be difficult to recover due to suboptimal specimen transport and/or storage conditions and lack of proper culture procedures. Several culture media formulations have been developed, some blood-based other including charcoal. Each of these media have shown to be a mediocre compromise between specificity and sensitivity.
Intended Use :
CHROMagar™ Campylobacter is a selective chromogenic culture medium intended for use in the qualitative direct detection, differentiation and presumptive identification of thermotolerant Campylobacter. The test is performed with rectal swabs and stools, to aid in the diagnosis of Campylobacter infections. Results can be interpreted after 36-48 h of micro-aerophilic incubation at 42 °C.
Concomitant cultures are necessary to recover organisms for further microbiological testing or epidemiological typing.
A lack of growth or the absence of colonies on CHROMagar™ Campylobacter does not preclude the presence of Campylobacter.
CHROMagar™ Campylobacter is not intended to diagnose infection nor to guide nor monitor treatment for infections.
CHROMagar™ Campylobacter can also be used in the detection of Campylobacter in the analyses of food products for human consumption, animal feed and in environmental samples in accordance with the ISO 10272-1.
1. In accordante to ISO 10272-1 requirements as a selective medium for the detection of Campylobacter.
4. Highly selective: In addition, a reinforced sélectivité allows for a very clean plate, even with heavily flora loaded samples.

2. Easy reading: 36-48 h incubation at 42 °C. The intense red colored colonies on a translucent agar facilitates the reading compared to charcoal based agar.
3. High recovery rate : approx. 100 % Enumerating Campylobacter has never been so simple and so reliable.
Composition

Technical Documents
Scientific Publications
2023
EVALUACIÓN DEL DESEMPEÑO DIAGNÓSTICO DE MEDIOS DE CULTIVO CROMOGÉNICOS PARA EL AISLAMIENTO DE Campylobacterspp. EN MUESTRAS FECALES DE PACIENTES CON GASTROENTERITIS
📄 Publication2017
Comparison of four different selective media for the quantification of Campylobacter in poultry meat and rapid confirmation of suspect colonies
📄 Publication2017
Evaluation comparative de trois milieux de culture sélectifs: CHROMagar Campylobacter (CHROMagar), Karmali (Oxoid) et Campylosel (bioMérieux), pour la recherche des Campylobacter thermotolérants à partir des échantillons fécaux
📄 Publication2017
Evaluation of different Campylobacter jejuni isolates to colonize the intestinal tract of commercial turkey poults and selective media for enumeration
📄 Publication

Read more